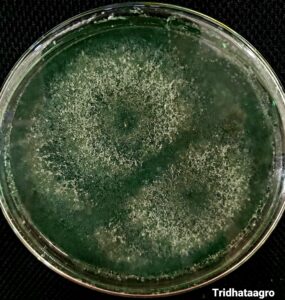
Trichoderma fungus as a biological agent

Umumnya, jamur (Kingdom: Fungi) memegang peranan penting dalam ekologi sebagai organisme saprofit atau pengurai. Namun, terdapat beberapa spesies jamur yang justru menyebabkan penyakit pada tanaman hingga dapat menurunkan produktivitas.
Fusarium adalah salah satu jamur yang merugikan karena menyebabkan penyakit pada cabai maupun tanaman-tanaman lainnya. Tanaman yang terinfeksi jamur Fusarium akan mengalami kematian dan menyebar dengan sangat cepat.
Contoh jamur merugikan lain adalah Ganoderma, jamur raksasa yang menyerang kelapa sawit. Kelapa sawit yang terserang Ganoderma akan mengalami pembusukan batang, penurunan produksi kelapa sawit yang signifikan, hingga kematian pada tanaman.
Pahlawan Tanaman
Sebagaimana pahlawan, Trichoderma hadir untuk membasmi jamur-jamur merugikan. Tak hanya Fusarium dan Ganoderma, jamur ini juga efektif untuk memberantas penyakit akibat jamur lain seperti penyakit busuk akar, karat daun, layu Phytopthora, busuk buah, karat pada kacang-kacangan, white mold, busuk umbi, head blight pada gandum dan jagung, penyakit terpadu pada tanaman hias, dan sebagainya.
Trichoderma dapat diaplikasikan pada berbagai tanaman pangan (padi, gandum, jagung, kedelai, kentang dan sayuran), tanaman hortikultura (cabai, mentimun, terong, tomat, dan sebagainya), tanaman perkebunan (kopi, cengkeh, lada, merica, tembakau, kapas, kakao), tanaman hutan, tanaman obat seperti ginseng dan kunyit, serta tanaman-tanaman lainnya.
Si Jamur Antagonis
Trichoderma memiliki hifa berwarna hijau tua yang mudah dijumpai di tanah dengan kandungan bahan organik tinggi ataupun di bagian tanaman yang membusuk. Uniknya, Trichoderma terkenal sebagai jamur antagonis karena dapat menghambat pertumbuhan jamur-jamur lain khususnya jamur yang merugikan tanaman.
Berbagai mekanisme pengendalian penyakit yang dilakukan oleh Trichoderma antara lain: melalui mekanisme antagonisme dengan cara bersaing sumber daya dan ruang, memproduksi enzim yang menghancurkan sel patogen, induksi ketahanan tanaman, dan memakan hifa jamur patogen. Sifat unik tersebut membuat Trichoderma terkenal sebagai pahlawan tanaman.
Apa Saja Peran Trichoderma Bagi Tanaman?
Sebagai pahlawan tanaman, si jamur hijau ini tak hanya mampu memberantas penyakit-penyakit pada tanaman tetapi juga meningkatkan kualitas pertumbuhan. Bahkan, tak seperti pupuk dan pestisida kimia yang dapat menimbulkan banyak dampak negatif, Trichoderma adalah agensi hayati yang aman dan ramah lingkungan. Luar biasa bukan? Kemampuan tersebut menjadikan jamur ini sebagai primadona yang sangat dicari-cari oleh petani. Beberapa peran penting lain dari Trichoderma diantaranya
- sebagai organisme pengurai yang menyuburkan tanah;
- meningkatkan efisiensi pemupukan;
- menciptakan sistem perakaran yang sehat;
- meningkatkan angka kedalaman akar;
- meningkatkan ketahanan tanaman terhadap stress lingkungan.
Bijaklah dalam Memilih
Saat ini telah banyak penawaran produk Trichoderma tanpa izin edar atau bahkan palsu di pasaran. Untuk memperoleh manfaat optimal seperti yang diharapkan, para petani sebaiknya memastikan keaslian produk yang akan digunakan. Tidak semua jenis Trichoderma memiliki efektivitas yang tinggi sebagai agensia hayati sehingga dibutuhkan identifikasi yang akurat oleh tim ahli.
Produk yang dikembangkan oleh Tridhataagro telah melalui serangkaian tahap penelitian, mulai dari isolasi, identifikasi, pemurnian biakan, perbanyakan, hingga pengujian skala laboratorium ataupun skala lapang yang dilakukan sesuai standar. Selain itu, produk Tridhataagro juga telah tersertifikasi sehingga terjamin kualitas dan efektivitasnya. Smart farming starts by choosing your products wisely. Planting for prosperity!

